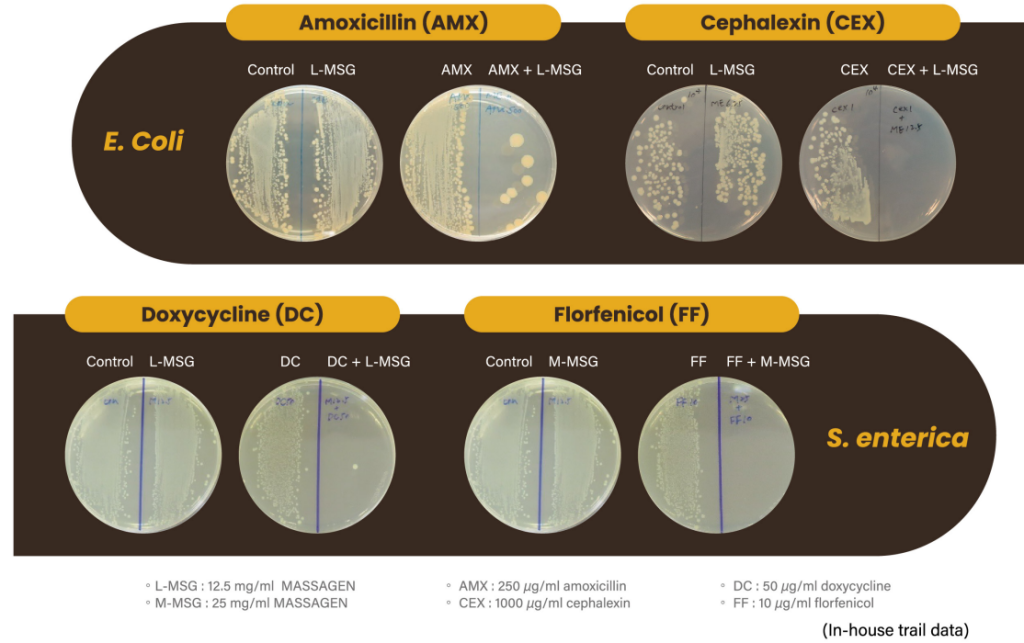

記者陳建興/台北報導
隨著環境變遷與污染日益嚴峻,循環經濟理念在全球的重要性不斷提升。京冠生物科技股份有限公司(京冠生技)秉持「以終為始、環境永續」的核心理念,結合經濟部產創計畫、SBIR計畫及環境部8+N資源循環聯盟的支持,專注於逆境固態發酵技術的精進,推動農食副產品的高值化應用。京冠生技楊青山董事長以永續發展為商機,結合農業循環經濟的核心精神,推動台灣農業創新,成功實現淨零轉型,也展現企業對循環經濟的實踐力。京冠生技最新推出以廢棄咖啡渣為原料的機能性飼料添加劑,針對全球抗生素抗藥性(Antimicrobial Resistance, AMR)問題提出創新解決方案,減少經濟動物抗生素的使用需求,推動畜產業朝向精準養殖與預防醫學的新方向發展;同時將台灣每年十萬噸廢棄咖啡渣轉化為40億元的產值,實現健康、安全與經濟效益的三贏。
隨著全球資源壓力日益加劇,台灣農食產業在線性經濟模式下面臨重重挑戰。作為綠色經濟的領航者,京冠生技以3R(Reduce減量、Reuse再利用、Recycle再循環)模式為基礎,前瞻性地引入Redefine(重新定義)與Redesign(重新設計)的創新思維,透過生物科技賦予農業廢棄物新價值,讓京冠生技不僅將「剩食」轉化為「盛食」,更為產業創造出一種可持續、共好的商業模式,促進產業發展與環境保護的雙贏局面。
京冠生技透過系統性跨域整合,攜手產官學各界,共同開啟全面性的綠色循環契機。以環境經濟與永續經營為核心理念,建成全台首座豆渣高值化減碳示範工廠,將生物、能源、水與碳的循環創新整合於生產流程中,樹立台灣循環經濟的新典範。此外,京冠生技為全台灣第一家成功研發綠豆固態發酵技術與菌種研發的生技公司。透過以生質材料為開發原料,微生物逆境固態發酵仿生技術和生醫分析手法,成功將茶渣、咖啡渣、豆渣等轉化為功能性飼料原料與人類保健產品,並持續精進技術,探索更多農食副產物再利用的可能性。
京冠生技深耕農業廢棄物高值化領域十餘年,專注於農食副產物的技術創新與應用,致力於打造從產地到餐桌的循環經濟生態鏈。隨著全球對永續畜牧與食品安全的關注日益增加,抗藥性問題已成為畜牧產業與公共健康共同面臨的重大挑戰。
針對此需求,京冠生技發掘廢棄咖啡渣的潛在價值,攜手多家科研單位開發出創新的「咖啡渣發酵產物」,為業界提供兼具環保與健康效益的突破性解決方案。嘉義大學獸醫系郭鴻志教授指出,抗生素的過度使用雖帶來醫學與動物健康的進步,但也加劇了細菌抗藥性問題,促使人類與動物醫學領域積極尋找減少抗生素使用(翦抗)或抗生素替代方案(替抗),咖啡渣發酵產物能顯著提升經濟動物細菌對抗生素的敏感性,有效抑制細菌的抗生素輸出幫浦,增強抗生素效用,進一步減少抗生素使用需求。基於此,京冠生技推出以廢棄咖啡渣為原料的功能性飼料添加劑,助力產業實現精準用藥與預防醫學的願景,重塑抗生素的價值與重要性。
不僅如此,經實驗證實「咖啡渣發酵產物」的應用潛力對人類健康也展現出突破性可能。研究結果顯示,該技術對人類肺炎黴漿菌(Mycoplasma pneumoniae)具有顯著抑制效果,未來有望發展為人類治療或預防藥物。目前,這項創新技術已成功取得台灣與日本多項專利,為解決公共健康問題提供全新的視角與契機。